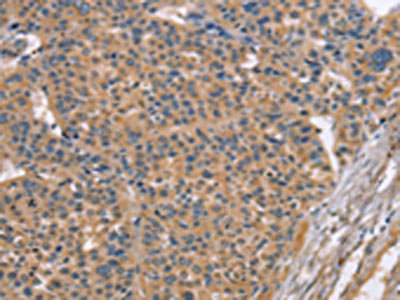

MAPK15 Antibody
-
中文名稱:MAPK15兔多克隆抗體
-
貨號:CSB-PA963449
-
規格:¥1100
-
圖片:
-
The image on the left is immunohistochemistry of paraffin-embedded Human lung cancer tissue using CSB-PA963449(MAPK15 Antibody) at dilution 1/20, on the right is treated with fusion protein. (Original magnification: ×200)
-
The image on the left is immunohistochemistry of paraffin-embedded Human liver cancer tissue using CSB-PA963449(MAPK15 Antibody) at dilution 1/20, on the right is treated with fusion protein. (Original magnification: ×200)
-
-
其他:
產品詳情
-
Uniprot No.:
-
基因名:
-
別名:ERK-7 antibody; ERK-8 antibody; ERK7 antibody; ERK8 antibody; Extracellular regulated kinase 8 delta antibody; Extracellular signal regulated kinase 8 antibody; Extracellular signal-regulated kinase 7 antibody; Extracellular signal-regulated kinase 8 antibody; MAP kinase 15 antibody; MAPK 15 antibody; Mapk15 antibody; Mitogen activated protein kinase 15 antibody; Mitogen-activated protein kinase 15 antibody; MK15_HUMAN antibody
-
宿主:Rabbit
-
反應種屬:Human
-
免疫原:Fusion protein of Human MAPK15
-
免疫原種屬:Homo sapiens (Human)
-
標記方式:Non-conjugated
-
抗體亞型:IgG
-
純化方式:Antigen affinity purification
-
濃度:It differs from different batches. Please contact us to confirm it.
-
保存緩沖液:-20°C, pH7.4 PBS, 0.05% NaN3, 40% Glycerol
-
產品提供形式:Liquid
-
應用范圍:ELISA,IHC
-
推薦稀釋比:
Application Recommended Dilution ELISA 1:2000-1:5000 IHC 1:25-1:100 -
Protocols:
-
儲存條件:Upon receipt, store at -20°C or -80°C. Avoid repeated freeze.
-
貨期:Basically, we can dispatch the products out in 1-3 working days after receiving your orders. Delivery time maybe differs from different purchasing way or location, please kindly consult your local distributors for specific delivery time.
-
用途:For Research Use Only. Not for use in diagnostic or therapeutic procedures.
相關產品
靶點詳情
-
功能:Atypical MAPK protein that regulates several process such as autophagy, ciliogenesis, protein trafficking/secretion and genome integrity, in a kinase activity-dependent manner. Controls both, basal and starvation-induced autophagy throught its interaction with GABARAP, MAP1LC3B and GABARAPL1 leading to autophagosome formation, SQSTM1 degradation and reduced MAP1LC3B inhibitory phosphorylation. Regulates primary cilium formation and the localization of ciliary proteins involved in cilium structure, transport, and signaling. Prevents the relocation of the sugar-adding enzymes from the Golgi to the endoplasmic reticulum, thereby restricting the production of sugar-coated proteins. Upon amino-acid starvation, mediates transitional endoplasmic reticulum site disassembly and inhibition of secretion. Binds to chromatin leading to MAPK15 activation and interaction with PCNA, that which protects genomic integrity by inhibiting MDM2-mediated degradation of PCNA. Regulates DA transporter (DAT) activity and protein expression via activation of RhoA. In response to H(2)O(2) treatment phosphorylates ELAVL1, thus preventing it from binding to the PDCD4 3'UTR and rendering the PDCD4 mRNA accessible to miR-21 and leading to its degradation and loss of protein expression. Also functions in a kinase activity-independent manner as a negative regulator of growth. Phosphorylates in vitro FOS and MBP. During oocyte maturation, plays a key role in the microtubule organization and meiotic cell cycle progression in oocytes, fertilized eggs, and early embryos. Interacts with ESRRA promoting its re-localization from the nucleus to the cytoplasm and then prevents its transcriptional activity.
-
基因功能參考文獻:
- Our results describe a primary cilia-related role for this poorly studied member of the MAPK family in vivo, and indicate a broad requirement for MAPK15 in the formation of multiple ciliary classes across species. PMID: 29021280
- High MAPK15 expression is associated with male germ cell tumors. PMID: 26988910
- In HeLa cells, phosphorylation of HuR by ERK8 prevents it from binding to PDCD4 mRNA and allows miR-21-mediated degradation of PDCD4. PMID: 26595526
- depletion of endogenous MAPK15 expression inhibited BCR-ABL1-dependent cell proliferation, in vitro PMID: 26291129
- The present study suggests that MAPK15 overexpression may contribute to the malignant transformation of gastric mucosa by prolonging the stability of c-Jun. PMID: 26035356
- ERK8 appears as a constitutive brake on N-Acetylgalactosaminyltransferase relocalisation, and the loss of its expression could drive cancer aggressivity through increased cell motility. PMID: 24618899
- Data suggest that the model coulb be a tool for the development of specific ERK8 kinase inhibitors. PMID: 23326322
- ATG8-like proteins (MAP1LC3B, GABARAP and GABARAPL1) are novel interactors of MAPK15/ERK8, a MAP kinase involved in cell proliferation and transformation. PMID: 22948227
- a novel function for ERK8 as a bona fide ERRalpha corepressor, involved in control of its cellular localization by nuclear exclusion, and suggest a key role for this MAP kinase in the regulation of the biological activities of this nuclear receptor. PMID: 21190936
- Data show that ERK8 prevents HDM2-mediated PCNA destruction by inhibiting the association of PCNA with HDM2, and implicate ERK8 in the regulation of genomic stability. PMID: 20733054
- Extracellular signal-regulated kinase 8-mediated c-Jun phosphorylation increases tumorigenesis of human colon cancer PMID: 20395206
- ERK8, a new member of the mitogen-activated protein kinase family. PMID: 11875070
- The activity of ERK8 in transfected HEK-293 cells depends on the relative rates of ERK8 autophosphorylation and dephosphorylation by one or more members of the PPP family of protein serine/threonine phosphatases. PMID: 16336213
- Erk8 has a role as a novel effector of RET/PTC3 and, therefore, RET biological functions PMID: 16484222
- human ERK8 has a role as a negative regulator of human GRalpha, acting through Hic-5 PMID: 16624805
- Regulation of the activity and expression of DERK8 by DNA damage are reported. PMID: 19166846
顯示更多
收起更多
-
亞細胞定位:Cytoplasm, cytoskeleton, cilium basal body. Cell junction, tight junction. Cytoplasm, cytoskeleton, microtubule organizing center, centrosome, centriole. Cytoplasmic vesicle, autophagosome. Golgi apparatus. Nucleus. Cytoplasm. Cytoplasm, cytoskeleton, spindle.
-
蛋白家族:Protein kinase superfamily, CMGC Ser/Thr protein kinase family, MAP kinase subfamily
-
組織特異性:Widely expressed with a maximal expression in lung and kidney.
-
數據庫鏈接:
Most popular with customers
-
-
YWHAB Recombinant Monoclonal Antibody
Applications: ELISA, WB, IHC, IF, FC
Species Reactivity: Human, Mouse, Rat
-
-
-
-
-
-